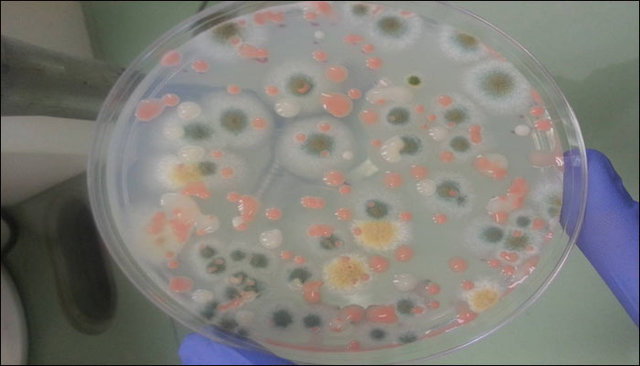

دانشمندان موفق به کشف میکرو ارگانیسمهایی شدند که در کریستالهای معدن مکزیک از 60،000 سال پیش به دام افتادهاند.
"پنهلوپه بوستون" دانشمند موسسه اخترزیست شناسی ناسا اعلام کرد که این میکروبها در طول زمان تکامل یافته به طوریکه میتوانند در سولفیت، منگنز و اکسید مس زنده بمانند.
وی اعلام کرد این کشف دارای اثرات عمیقی بر درک ما از تاریخ تکامل حیات میکروبی در این سیاره است.
این معدن که در آن میکروب یافت شده معدن نایکا(Naica) نام داشته و معدن زینک و نقره در ایالت شمالی "چیهواهوا" مکزیک است که به داشتن کریستالهای بزرگ معروف است که برخی از آنها به بلندی 50 فوت (15 متر) است.
بوستون بر این باور است که این موجودات زنده همچنین میتوانند در شرایط سخت دیگر سیارات و قمرها در منظومه شمسی زنده بمانند.
این دانشمند اعلام کرد که در حدود 100 نوع مختلف از میکروارگانیسم ها که بسیاری از آنها باکتری بودند در بلورهای Naica و در دورههای مختلف 10،000 تا 60،000 سال حبس شده اند که 900 درصد آنها تاکنون کشف نشده اند.
اخترزیست شناسان همچنان در مورد خطر اینکه موجودات زمینی میتوانند سیارات دیگر مانند مریخ را آلوده کنند نگران هستند.
ناسا قبل از ارسال فضاپیما و تجهیزات آن به فضا آنها را ضد عفونی میکند اما همیشه خطر زنده ماندن میکروارگانیسمهای مقاوم وجود دارد.
البته این نگرانی جدید نبوده زیرا در طول ماموریتهای آپولو که از سال 1960 تا سال 1970 به طول انجامید، فضانوردان پس از بازگشت از ماه قرنطینه شدند.
همچنین میکرو ارگانیسمهای موجود در معدن Naica قدیمیترین موجوداتی که تا به امروز کشف شدهاند نیستند.
چند سال پیش دانشمندان موفق به پیدا کردن میکروبهایی در یخ و نمک شدند که 500،000 سال قدمت داشتند.
